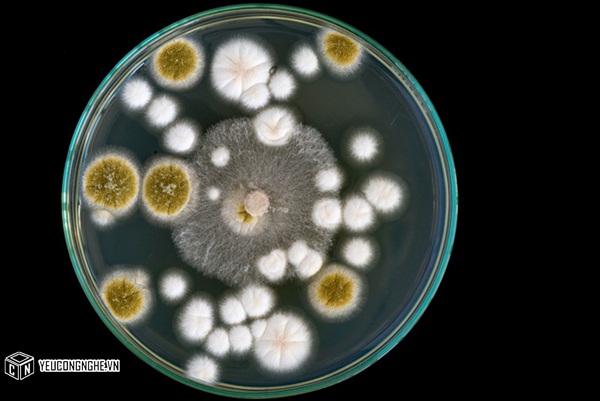

Có rất nhiều phát minh quan trọng trong quá khứ được tìm ra một cách rất tình cờ.
Bạn có tin sau khi một thanh sô cô la tan chảy trong túi của người này khiến một người khác trở thành triệu phú?
Tính không cẩn thận của một nhà khoa học đã giúp nhân loại có một loại thuốc chữa bách bệnh thần kì.
Dưới đây là những câu chuyện như vậy.
1. Kháng sinh Penicillin
Người phát minh: Alexander Fleming.
Năm: 1928.
Điều gì đã xảy ra: Đang làm thí nghiệm với vi khuẩn, Alexander Fleming bỏ đi ngủ. Tính không cẩn thận, ông quên mất một đĩa thí nghiệm bẩn trong bồn rửa.
Phát hiện quan trọng: Khi trở lại, ông quan sát thấy vi khuẩn phát triển trên đĩa, ngoại trừ một khu vực mà nấm mốc được hình thành.
Kết quả là: Penicillin được phát hiện. Vợ Fleming thuê một người giúp việc.
2. Gây tê

Người phát minh: Horace Wells.
Năm: 1844.
Điều gì đã xảy ra: Trong một lần Wells và bạn bè sử dụng khí cười N2O để chơi đùa. Một người bạn của ông đã xả nó quá nhiều vào chân.
Phát hiện quan trọng: Anh ta không cảm thấy chân mình bị đau khi tự đánh vào đó.
Kết quả là: N2O trở thành hình thức đầu tiên của gây tê.
3. Đường Saccharin

Người phát minh: Constantin Fahlberg và Ira Remsen
Năm: 1879.
Điều gì đã xảy ra: Sau khi dành một ngày nghiên cứu chất dẫn xuất nhựa than, Fahlberg rời phòng thí nghiệm Johns Hopkins và đi ăn tối.
Phát hiện quan trọng: Ông nếm được một cái gì đó rất ngọt. Nó bắt nguồn từ một hợp chất hóa học còn bám lại trên tay.
Kết quả là: Fahlberg bí mật nghiên cứu và lấy bằng sáng chế đường saccharin riêng cho mình. Hàng loạt sản phẩm đã được tạo ra biến ông thành triệu phú. Remsen và phòng thí nghiệm rất tức giận.
4. Lò vi sóng

Người phát minh: Percy Spencer.
Năm: 1946.
Điều gì đã xảy ra: Kết thúc chiến tranh thế giới thứ II, các kỹ sư đã tạo nên một hệ thống phát vi sóng cho radar. Trong khi Spencer đang đứng cạnh một thiết bị như vậy, thanh sô cô la trong túi anh tan chảy.
Phát hiện quan trọng: Vi sóng cũng có thể làm nổ bỏng ngô.
Kết quả là: Orville Redenbacher (một doanh nhân Mỹ) bán bỏng ngô và trở nên giàu có.
5. Thuốc Viagra

Người phát minh: Các nhà khoa học tại công ty Pfizer.
Năm: 1992.
Điều gì đã xảy ra: Một làng của xứ Wales được lựa chọn là nơi thử nghiệm thuốc chống đau thắt ngực. Thật không may cho những người phải chịu đựng những cơn đau, nó chẳng có tác dụng gì.
Phát hiện quan trọng: Dù không hiệu nghiệm, những người đàn ông không muốn ngừng sử dụng thuốc.
Kết quả là: Các nhà khoa học chuyển hướng nghiên cứu. Họ tiếp thị thuốc của họ theo mục đích nào thì bạn cũng biết rồi đấy.
6. Kẹo cao su

Người phát minh: Thomas Adams.
Năm: 1870.
Điều gì đã xảy ra: Ông thử sử dụng nhựa cây Chicle như là một thay thế cho cao su với mục đích làm giàu. Adams thất bại, ông thất vọng nhai một miếng nhựa cây trong miệng.
Phát hiện quan trọng: Ông thích nó!
Kết quả là: Adams vẫn giàu có. Ông phát triển thương hiệu “kẹo Adams số 1 New York”.
7. Đồ chơi Silly Putty

Người phát minh: James Wright.
Năm: 1943.
Điều gì đã xảy ra: Chiến tranh thế giới thứ II đòi hỏi nguồn cung cao su tổng hợp. Wright muốn tạo ra một chất thay thế. Ông vô tình trộn axit boric vào với silicon.
Phát hiện quan trọng: Nó tạo thành một hợp chất dẻo, nảy và đàn hồi.
Kết quả là: Trẻ em có một thứ đồ chơi thú vị.
8. Thuốc xóa nếp nhăn botox

Người phát minh: Alastair và Jean Carruthers.
Năm: 1987.
Điều gì đã xảy ra: Cặp đôi này sử dụng liều lượng nhỏ chất độc chết người này để điều trị rối loạn cơ mắt và co thắt mí.
Phát hiện quan trọng: Nếp nhăn trên mắt biến mất.
Kết quả là: Nhiều quý bà trở nên trẻ trung và xinh đẹp hơn.
9. Rượu mạnh

Người phát minh: Một thuyền trưởng người Hà Lan.
Năm: thế kỷ 16.
Điều gì đã xảy ra: Ông sử dụng một phương pháp nhiệt để cô đặc rượu lại, khiến nó dễ dàng vận chuyển hơn. Khi chuyến tàu cập bến, nước được pha lại để tạo rượu ban đầu.
Phát hiện quan trọng: Rượu cô đặc còn tuyệt hơn.
Kết quả là: Rượu 'brandewijn' ra đời và nổi tiếng ở Hà Lan. Vì phát âm tên nó rất khó, bạn có thể gọi nó là rượu mạnh (“Brandy” trong tiếng Anh). Người pha chế ở quầy sẽ hiểu ý bạn.
10. Thuốc nhuộm

Người phát minh: William Perkin.
Năm: 1856.
Điều gì đã xảy ra: Perkin cố gắng điều chế một loại thuốc để chữa sốt rét. Ông cố gắng nhân rộng hợp chất của mình trong phòng thí nghiệm.
Phát hiện quan trọng: Ông phát hiện ra màu cà tím của thuốc nhuộm mauveine sau này.
Kết quả là: Perkin quên luôn về việc điều trị sốt rét. Ông tạo ra một ngành công nghiệp thuốc nhuộm tổng hợp.
Theo Soha
Mời bạn xem thêm:
Các phát minh kỳ lạ ở thế kỷ 19
Những phát minh đi trước thời đại hàng triệu năm
20 phát minh kỳ cục đến khó hiểu